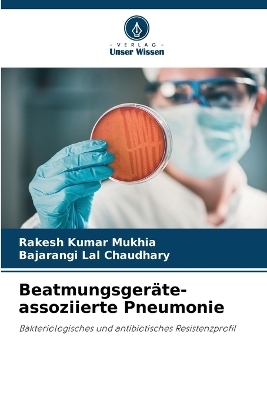
Beatmungsger&auml;te-assoziierte Pneumonie - Rakesh Kumar Mukhia, Bajarangi Lal Chaudhary

Beatmungsgeräte-assoziierte Pneumonie
Seiten
2024
Verlag Unser Wissen
978-620-8-25910-5 (ISBN)
Verlag Unser Wissen
978-620-8-25910-5 (ISBN)
- Titel nicht im Sortiment
- Artikel merken
Das Buch "Bacteriological and Antibiotic Resistance Profile of Ventilator-Associated Pneumonia" (Bakteriologische und antibiotische Resistenzprofile bei beatmungsassoziierter Lungenentzündung) ist für die Verbesserung der Patientenversorgung auf der Intensivstation unerlässlich. Es leitet Kliniker bei der Auswahl gezielter Antibiotikatherapien auf der Grundlage lokaler Erregerprofile an und hilft so, die Sterblichkeit zu senken und Antibiotikaresistenzen zu bekämpfen. Das Buch fördert den verantwortungsvollen Umgang mit Antibiotika, unterstützt die Überwachung von Resistenztrends und verbessert die Infektionskontrollprotokolle. Es ist eine Bildungsressource für Angehörige der Gesundheitsberufe und eine Referenz für die Entwicklung evidenzbasierter Leitlinien. Darüber hinaus bietet es eine Grundlage für die künftige Forschung und die Entwicklung von Strategien und trägt zu einer besseren Behandlung und Prävention von VAP weltweit bei.
Dr. Rakesh Kumar Mukhia (M.Sc., Ph.D. Medizinische Mikrobiologie) vom MGM Medical College & Hospital, Navi Mumbai, Indien. Dr. Mukhia hat sieben Jahre lang als außerordentlicher Professor in der Abteilung für Mikrobiologie am Hind Institute of Medical Sciences (HIMS), Sitapur, Uttar Pradesh, gearbeitet. Er hat mehr als 20 Forschungsartikel in renommierten Fachzeitschriften veröffentlicht.
| Erscheinungsdatum | 07.11.2024 |
|---|---|
| Sprache | deutsch |
| Maße | 152 x 229 mm |
| Gewicht | 122 g |
| Themenwelt | Naturwissenschaften ► Biologie ► Allgemeines / Lexika |
| Naturwissenschaften ► Biologie ► Mikrobiologie / Immunologie | |
| Schlagworte | antibiotic resistance • Antibiotikaresistenz • Bacteria • Bakterien • beatmungsassoziierte Lungenentzündung • Ventilator associted pneumonia |
| ISBN-10 | 620-8-25910-X / 620825910X |
| ISBN-13 | 978-620-8-25910-5 / 9786208259105 |
| Zustand | Neuware |
| Informationen gemäß Produktsicherheitsverordnung (GPSR) | |
| Haben Sie eine Frage zum Produkt? |
Mehr entdecken
aus dem Bereich
aus dem Bereich
Buch | Softcover (2024)
Wiley-VCH (Verlag)
CHF 55,85
Band 2: Elektrizität, Optik und Wellen
Buch | Softcover (2022)
Wiley-VCH (Verlag)
CHF 55,85
Vom Ursprung der Sexualitat zum modernen Menschen
Buch | Softcover (2025)
UTB (Verlag)
CHF 54,60


